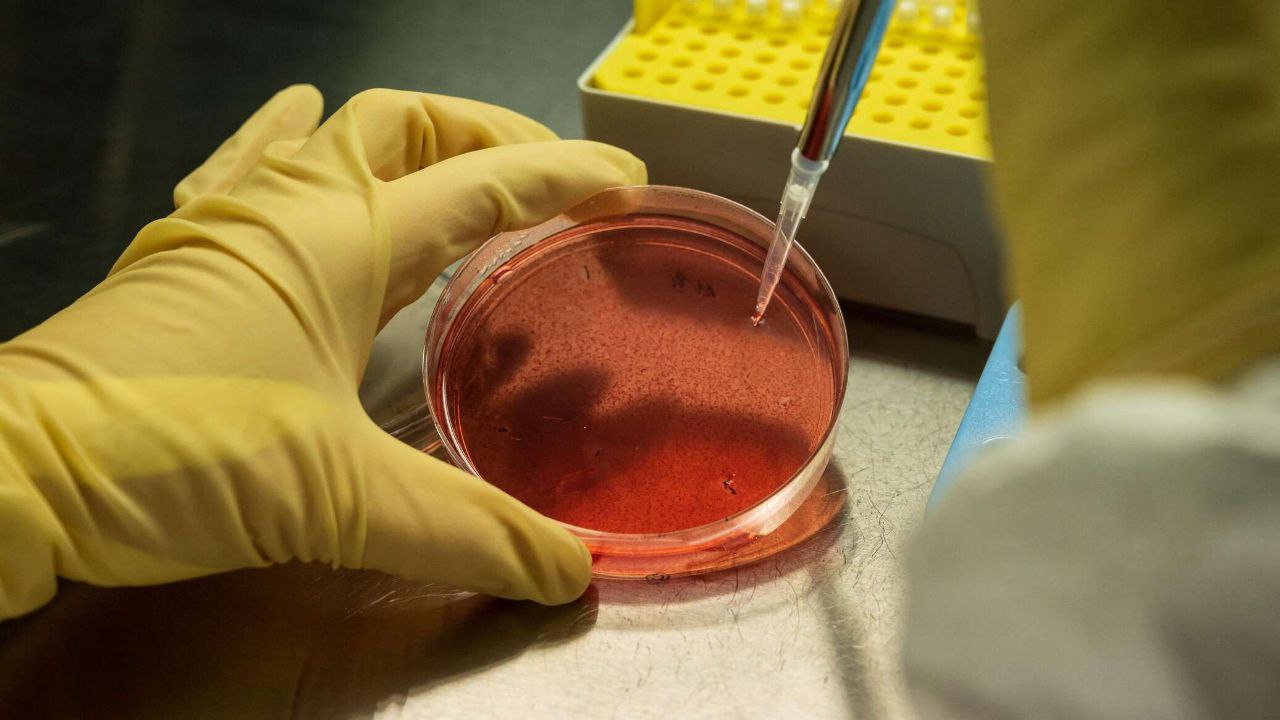

✔️Gepatit A kasalligining xavf guruhi ✔️Gepatit A kasalligi bo‘yicha xavf guruhiga quyidagilar kiradi: ✔️Oila a’zolari bo‘lgan, gepatit A bilan kasallangan odamlar; ✔️Virus yuqori tarqalgan hududlarda yashovchi odamlar. ✔️Gepatit A kasalligini oldini olish ✔️Gepatit A kasalligining oldini olish uchun quyidagilar tavsiya…

📌Gepatit E kasalligining belgilari 📌Gepatit E ning alomatlari gepatit A ning alomatlariga o‘xshaydi va quyidagilarni o‘z ichiga oladi: 📌Ko’zlarning sarg’ayishi; 📌Terining sariqligi; 📌Axlatning rangsizlanishi; 📌Umumiy darmonsizlik; 📌Isitma; 📌Arterial bosimning pasayishi; 📌Siydikning qorayishi; 📌Teridagi ko‘karishlar; 📌Qusadigan ko‘ngil aynish. 📌Gepatit E kasalligini…

✔️OIV kasalligining rivojlanish bosqichlari: ✔️1-bosqich (inkubatsiya bosqichi). Kasallik ilk paytidan kasallikning klinik belgilari paydo bo’lishigacha bo’lgan davr. Muddati: 2 haftadan 6-8 oygacha. Testlar virus mavjudligini aniqlay olmaydigan bosqich, ammo u allaqachon sheriklar va qabul qiluvchilarga yuqadi. ✔️2-bosqich (birlamchi yoki faol…

📌Meningitni davolash 📌Meningitni davolash quyidagilarni o‘z ichiga oladi: 📌Antibiotiklar (bakterial shaklda); 📌Sulfanilamidlar; 📌Umumiy quvvatlantiruvchi preparatlar (vitaminlar, glyukoza, analgin); 📌Kortikosteroidlar va diuretiklar; 📌Takroriy orqa miya punksiyalari (og‘ir holatlarda). 📌Xavf 📌Meningitni o‘z vaqtida davolashning yo‘qligi jiddiy oqibatlarga olib kelishi mumkin: 📌Bosh miyaning…
✅Vabo kasalligining diagnostikasi. ✅Vabo tashxisi infeksionist vrach tomonidan qo‘yiladi. Buning uchun quyidagi tahlillar va tadqiqotlar tayinlanadi: ✅qusish massalari, axlat massalari va ichak suyuqligini bakteriologik ekish; ✅serologik tadqiqotlar; ✅vibrionlarning mikroagglyutinatsiyasi va immobilizatsiyasi. ✅Vabo kasalligini boshqa ichak infeksiyalaridan (masalan, salmonellyoz va dizenteriya)…

✅Immunizatsiya haftaligi-bu global tashabbus: ✅Immunizatsiya haftaligi — har yili Jahon sog’liqni saqlash tashkiloti (JSST) tomonidan tashkil etiladigan global tadbir. U aprel oyining oxirgi haftasida o’tkaziladi. ✅Immunizatsiya haftaligining maqsadi: ✅Immunizatsiyaning ahamiyati haqida xabardorlikni oshirish. ✅Immunizatsiya qamrovini oshirish, ayniqsa qiyin erishiladigan hududlarda.…
✅Immunizatsiya-sog’lom jamiyat poydevori! ✅Immunizatsiya, ko’pincha emlash deb ataladi, bu organizmni kasalliklarga qarshi himoya qilish usuli. U organizmga ma’lum bir kasallik qo’zg’atuvchisiga o’xshash moddani kiritish orqali immunitetni shakllantirishga asoslangan. Bu organizmning immun tizimini faollashtiradi va kelajakda ushbu kasallik bilan uchrashganda uni…
